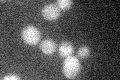
YIL067C
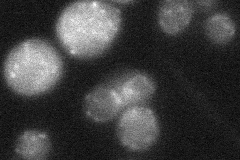
YIL067C
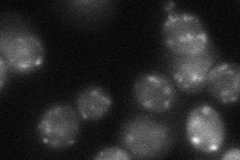
YIL067C
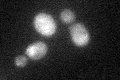
YIL067C

View description
Uncharacterized protein of unknown function
Localization:
Intensity:
Fold change:
Significance:
-
C’ GFP library in SD
below threshold14.45 -
N' NOP1pr-GFP in SD

punctate57.6079 -
N' TEF2pr-mCherry in SD

punctate73.5281 -
N' NATIVEpr-GFP in SD
punctate21.5808 -
N' TEF2pr-VC and Cyto-VN in SD
punctate39.9673 -
C’ GFP library in SD+DTT
cytosol14.671.01No -
C’ GFP library in SD+H2O2

cytosol13.880.96No -
C’ GFP library in Starvation Media

cytosol18.171.25No -
C’ GFP library on the background of Pup2-DaMP

below threshold -
C’ GFP library on the background of CCT mutant

below threshold14.02140.970307No
